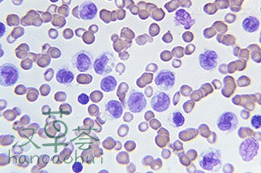

漢草薈松針靈芝規格和說明
產品名稱:漢草薈松針靈芝配方

產品規格:8g/餅*12餅
用法用量:以1柄為單位,以靈芝養生壺沖泡,2-6分鐘,即可完全提取
使用周期:3筒為一個周期,一個周期可服用18天,可看到明顯效果。
主要功效:配合放化療、手術使用,能提高人體免疫力、使血小板、白細胞、紅細胞正常化、配合放化療服用,對癌細胞抑制率高達99%、防止癌細胞復發轉移、延長癌症患者的生命周期,減輕放化療毒副作用,並能起到增效解毒的作用。
適宜人群:癌症患者、放化療患者、日常養生防癌人群
授權生成商:泛生中藥飲片有限公司
生產許可編號:QS4413 1402 0109
流通許可:SP4401061010009245
藥品GMP證書編號:粵H0421
藥品生產許可證號:粵Y20060536
衛生許可證:粵衛食證字[2006]第1300A00032號
服用功效
1、診斷階段服用松針靈芝配方
確診為腫瘤,但未確定治療方案時,可利用30天左右的等待期,服用松針靈芝配方,可迅速提高機體免疫系統,為臨床治療做準備。
2、手術前後服用松針靈芝配方
對於能進行手術治療的病人,術前一周開始服用松針靈芝配方能控制腫瘤的生長、擴散、抑制瘤體生長,穩定改善病情,並能通過提高機體的免疫功能,改善病人的全身狀況,為成功實施手術及術後恢復奠定良好基礎。

放化療前服用松針靈芝配方,可以及早控制腫塊,為患者贏得治療時機,高齡、體弱、免疫能力低的患者更加適用。
4、與放化療同步服用松針靈芝配方
癌症患者配合放化療治療,服用松針靈芝配方,可以提高腫瘤細胞對放化療的敏感度,消除其抗藥性,增強放化療療效,同時還可以大大減輕放化療的毒副作用,提升白細胞、紅細胞和血小板數量。
大量臨床結果表明:腫瘤患者神疲乏力、無法入睡、白細胞低、腹脹、疼痛、噁心、食慾不良、咳嗽、腹瀉、嘔吐、便秘等症狀均有明顯改善,生活質量提高。患者一般在服用松針靈芝配方後五天到十天睡眠、食慾明顯改善,服用一個療程後再次放化療時,噁心、嘔吐、厭食、白細胞下降等毒副症狀基本消失。
5、放化療後服用松針靈芝配方
臨床顯示:放化療後使用松針靈芝配方能防止腫瘤的轉移與復發,還能提高放化療後的恢復速度,增強患者體質,減輕放化療毒副作用,提高放化療患者生存質量。
6、晚期腫瘤患者服用松針靈芝配方
對於晚期癌症病人,病情嚴重,無法手術切除,亦無法進行放化療,服用松針靈芝配方能迅速改善病情,顯著提高病人的食慾,改善精神狀態,減輕病狀,緩解疼痛,一定程度上恢復生活自理能力,提高腫瘤患者的生存質量。
7、日常養生防癌人群服用松針靈芝配方
癌症治療起來比較困難,而且對身體傷害很大。事實上,在日常生活中,養成一些健康的生活習慣,是可以預防癌症的。松針靈芝是本草綱目中的上藥珍品,藥食兩用,從人體五臟內進行調理,重建免疫平衡,是日常養生防癌輔助佳品!
專家研究
A、權威專家:直井幸雄--日本生物學家
松針靈芝配方對腫瘤細胞端粒酶起作用,抑制端粒酶的活動可有效抑制細胞的生長。用人肝癌細胞(SMMC-7721)、人肺癌細胞(H460)、人白血病細胞(K562)、Lewis肺癌細胞株,觀察用松針靈芝配方對各種腫瘤細胞端粒酶活性作用結果,發現人肝癌細胞(SMMC-7721)、人肺癌細胞(H460)、人白血病細胞(K562)、Lewis肺癌細胞株端粒酶活性均降低,證明松針靈芝配方可明顯抑制腫瘤細胞端粒酶的活性。
B、權威專家:Shu--台灣生物學家

C、權威專家:YeungH.Y教授--美國生物家
進行松針靈芝配方多糖的提取及對小鼠免疫功能影響的研究,每天灌胃0.5克或1.0毫克/千克體重的松針靈芝配方多糖(GLP),連續25天,可明顯促進小鼠特異性抗體的形成,促進小鼠巨噬細胞的吞噬功能,增加外周血T淋巴細胞數量,延緩胸腺萎縮,並可對抗由Y所致的細胞免疫和體液免疫低下的作用,證明松針靈芝配方能抑制腫瘤的生長,能增加NK細胞的活性,提高單核-吞噬細胞的吞噬功能,能抑制腫瘤的生長,增強機體的免疫功能,有確切的效果。
實驗效果
實驗一:松針靈芝配方可明顯抑制腫瘤細胞端粒酶的活性!
松針靈芝配方對腫瘤細胞端粒酶起作用。端粒酶是核糖酸和蛋白的複合物,是一種特殊的DNA聚合酶,利用自身的RNA做模板合成端粒的DNA聚合酶。近年來發現,端粒酶長度隨細胞分裂次數增加而縮短,正常細胞分裂多次後端粒酶縮短達到危機點,細胞停止分裂,隨即衰老,死亡,少數細胞逃逸危機點,激活端粒酶,從而永生,發生惡變。因此,抑制端粒酶的活動可有效抑制癌細胞的生長。用人肝癌細胞(SMMC-7721)、人肺癌細胞(H460)、人白血病癌細胞(K562)、觀察用松針靈芝配方對各種腫瘤細胞端粒酶活動性作用結果,發現人肝癌細胞(SMMC-7721)、人肺癌細胞(H460)、人白血病癌細胞(K562)端粒酶活性均降低,證明松針靈芝配方可明顯抑制腫瘤細胞端粒酶的活性!

健康昆明品系小鼠以松針靈芝配方灌胃,用環磷醯胺(CY)腹腔注射液誘導產生骨髓嗜多染紅細胞微核後,進行微核試驗測定微核出現的千分率。S180瘤源小鼠瘤細胞接種於健康小鼠體內,14天后取出瘤塊進行瘤重比較,結果:松針靈芝配方可明顯降低環磷醯胺所致小鼠骨髓嗜多染紅細胞微核率,也能抑制S180移植性腫瘤生長。證明松針靈芝配方能抑制或對抗細胞染色體的突變,具有一定抗腫瘤作用。
實驗三:松針靈芝配方有抑制腫瘤細胞生長的作用!
用松針靈芝配方提取物抑制腫瘤細胞生長進行實驗研究,證實高濃度、高劑量的松針靈芝配方提取物有抑制腫瘤細胞生長的作用,松針靈芝配方乙醇提取物和三萜類成分對體內培養的腫瘤細胞則有直接細胞解毒的作用,如給實驗小鼠靈芝多糖,對實驗小鼠移植S180肉瘤有抑制作用,抑制率為54.1%-87.6%,實驗發現,松針靈芝配方提取物體內給藥可抑制動物移植性腫瘤生長,但對體外培養的腫瘤細胞多無直接細胞毒作用,松針靈芝配方及其所含多糖既不能直接抑制或殺死腫瘤細胞,又不能直接誘導細胞凋亡!
漢草薈松針靈芝配方改善癌細胞的原理
眾所周知,癌細胞是突變了的細胞。一旦突變之後,與正常細胞完全不一樣,它的生命力極強,能瘋狂地、無休止地分裂增殖,腫塊迅速長大,消耗大量的人體營養,使人迅速消瘦,同時侵犯重要臟器,導致病人死亡。
癌細胞為什麼會永生不死呢?原來它含有一種“端粒酶”。無論是正常細胞和癌細胞,其染色體的兩端都各有一段染色粒,稱為端粒。端粒的功能是保護染色體的完整性和穩定性。正常細胞每分裂一次,端粒就要縮短一些,經過若干次分裂之後,端粒消耗殆盡,細胞便老化、衰亡。而癌細胞的特殊之處,就在於它有端粒酶,此酶能保護端粒在細胞分裂時不受損耗,因此端粒並不縮短。正因為此,癌細胞能無限制地分裂下去。
近期研究指出,靈芝提取物中的多糖、肽類、酶類、有機鍺等成分,能滲透到癌細胞中,與端粒形成共價結合,破壞端粒酶的活性。癌細胞中的DNA(脫氧核糖核酸)一旦失去端粒酶的保護,則每分裂1次就縮短1次,最後,癌細胞便停止分裂而凋亡。這是抑制癌細胞生長複製轉移的又一機理。

由此可見,靈芝及其製劑對防禦癌細胞生長擴散轉移有肯定的效果,是抑制癌症的武器之一。但還應該清醒地看到,在目前,癌症的改善仍應首先選用手術療法、化療、放射療法,僅靠靈芝是不行的。而在手術前後,或化療放療的同時,套用靈芝,則既能增強抗癌的效果,又能減少放化療的毒副作用,不失為一種良好的選擇。
漢草薈松針靈芝配方抗癌研究
中國醫學科學院藥物研究所研究結果證實:松針靈芝的藥理成份非常豐富,富含60多種對人體有益的成份,能有效抑制腫瘤細胞生長,對多種腫瘤細胞如食道癌、胃癌、結腸癌、鼻咽癌、淋巴癌、肺癌、肝癌、胰腺癌、乳腺癌、血癌等都有明顯的抑制作用!
科學研究表明:松針靈芝能有效抑制癌細胞生長,提高人體自身的免疫細胞及抑瘤基因活性,有效防止“二次瘤”的出現,在所有靈芝中以松針靈芝抑制腫瘤效果最好!
漢草薈松針靈芝配方對腫瘤人群有免疫調節、輔助抑制腫瘤、抗突變,有抗化學性肝損傷的良好作用,是目前腫瘤綜合治療中除手術、放化療外的不可缺少的生物免疫治療。配合放化療使用,效果更明顯,可從細胞內、外防止腫瘤的發生、發展和轉移,可有效消除或減輕晚期病人的痛苦,帶瘤生存,提高生存質量,是最人性化的治療手段。臨床檢驗證明,漢草薈松針靈芝配方高效、安全、無毒,適合處於不同治療階段的腫瘤患者:
1、對正在進行放化療的患者:減輕放化療對身體形成的骨髓抑制,增強放化療效果,減輕嘔吐、食欲不振、睡眠不好、白細胞減少等放化療後的毒副作用,防止腫瘤的復發與轉移,提高治癒率!
2、對無法再進行放化療的腫瘤患者:可控制腫瘤的繼續惡化生長、擴散、延長帶瘤生存時間,並能有效地消除癌痛、積水等,提高病人生存質量,減低痛苦,延長生命時間。
3、對康復期的腫瘤患者:能增加飲食、改善睡眠、增加免疫力、加速恢復體質,防止殘留的腫瘤細胞捲土重來,顯著減低腫瘤復發轉移率,有效防癌抗癌。
經大量臨床及科學實驗證實:漢草薈松針靈芝配方用於配合惡性腫瘤患者的放療、化療,能增強病人的耐藥性,減輕放化療毒副作用,改善骨髓造血功能,使白細胞,紅細胞,血小板正常化,防止癌細胞的轉移、復發,增強機體抗病毒免疫能力,促進康復,是目前配合放化療最有效的腫瘤治療方法。晚期癌症患者服用後可增強體質和抗癌能力,緩解放化療後併發症的發生和發展,延長存活期,提高生存質量。在患者化療中的作用是無法估量的,使廣大癌症患者看到了希望,漢草薈松針靈芝配方減輕癌症的威脅,儘量享受現代科技和中醫文化帶給您的方便與快捷,幫助腫瘤患者順利度過放化療的治療階段,成功地戰勝了病魔,走向健康!
